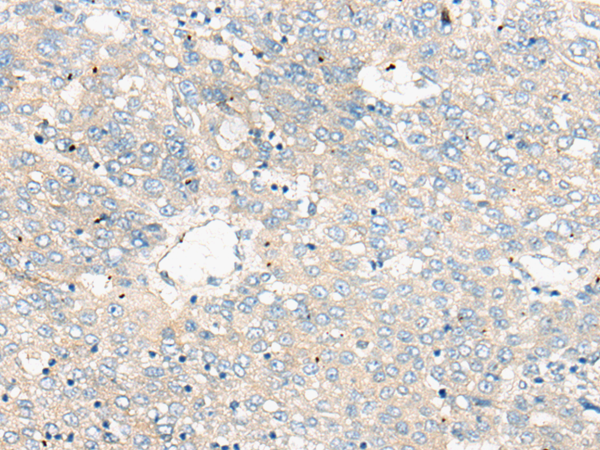

-
分类: 科研抗体货号: P09238别名:应用: IHC反应种属: Human
-
分类: 科研抗体货号: P09220别名: TTP; G0S24; GOS24; TIS11; NUP475; zfp-36; RNF162A应用: IHC反应种属: Human, Mouse, Rat
-
分类: 科研抗体货号: P09237别名: HSD16; MST154; ZNF327; MSTP154; ZNF135L; ZNF140L应用: IHC反应种属: Human
-
分类: 科研抗体货号: P09248别名:应用: IHC反应种属: Human, Mouse
-
分类: 科研抗体货号: P09235别名: ZF2; HFB101; ZSCAN51; ZKSCAN19应用: IHC反应种属: Human
-
分类: 科研抗体货号: P09247别名: NIZP1; ZFP496; ZSCAN49; ZKSCAN17应用: WB,IHC反应种属: Human, Mouse
-
分类: 科研抗体货号: P09234别名: HZF1应用: IHC反应种属: Human
-
分类: 科研抗体货号: P09244别名: ZSCAN19应用: IHC反应种属: Human
-
分类: 科研抗体货号: P09261别名: CR; TC; DAF; CROM应用: WB,IHC反应种属: Human
-
分类: 科研抗体货号: P09243别名: HTF6; KOX27; ZNF39L1应用: IHC反应种属: Human

鄂公网安备42018502007531号
鄂公网安备42018502007531号

